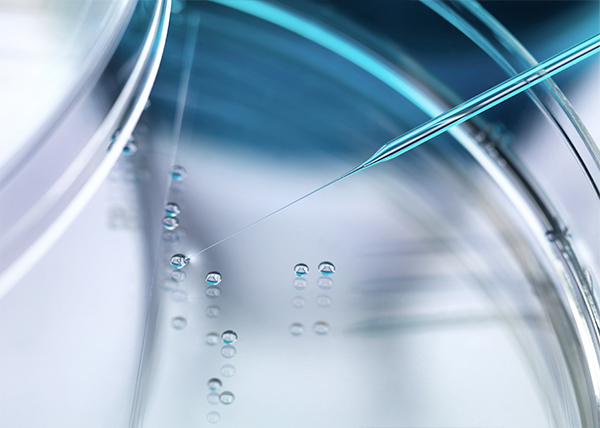

피부탄력·모공·흉터·노화관리 목적의 근본적인 재생을 목표로 합니다.
혈액에서 추출한 세포로, 되찾는 젊음 생기
르로제 BC 안티에이징
Liposuction
노화는 세포 활력이 떨어지는 순간부터 시작됩니다.
르로제의 BC 프로그램은 내 혈액에서 추출한 세포를 활용해
피부와 몸의 세포를 되살리는 프리미엄 안티에이징 케어입니다.
내 혈액으로 만드는, 절개 없는 세포 재생 솔루션

BC 란?
혈액에서 추출한 성체줄기세포 기반의 ‘자가 세포재생 주사’
BC(Blood Cell) 는 혈액에서 채취한 고순도 성체줄기세포와
성장인자, 면역조절 인자가 함께 작용하는 세포재생 농축액입니다.
BC 세포 구성요소
- 조혈모세포 : 손상 세포 복원, 재생 촉진
- 중간엽줄기세포 : 피부·연골 등으로 분화, 콜라겐 재생
- 성장인자 (EGF, FGF 등) : 피부탄력·혈류 개선, 주름 완화
- 사이토카인 : 염증 억제, 면역 조절
- 백혈구·혈소판 : 상처 치유, 피부결 회복 보조
Why?
왜 BC 인가?
르로제만의 BC 안티에이징 솔루션
-
01
100% 내 혈액 기반, 자연 회복
자가세포이므로 이물감·거부반응 걱정 없이자연스럽고 안전하게 회복됩니다.

-
02
절개 없는 비수술 안티에이징
혈액 채취만으로 시술 완료. 마취·흡입·절개 없이 일상 복귀 가능합니다.

-
03
피부에서 전신까지 작용
피부 탄력, 주름개선은 물론 피로회복·면역력 강화·탈모개선 등 전신 세포 활성까지 가능합니다.

세포부터 리셋하는 4단계 회복
SVF 안티에이징과의 차이점은?
| 구분 | BC | SVF |
|---|---|---|
| 채취 부위 | 혈액 | 지방조직 |
| 포함 인자 | 혈액세포, 성장인자 면역인자 | 지방유래세포, 내피세포 |
| 핵심 작용 | 세포 활성, 피부탄력 개선자 | 볼륨 복원 필요자 |
| 적합 대상 | 우수 (피부, 조직에 특화) | 보통 |
BC 안티에이징 시술 방식 안내
1
피부 직접 주사 방식
“피부 깊숙이, 재생의 신호를 전달하다”
피부 주사 방식은 BC를 고농축 상태로 피부 진피층에 직접 주입하여 손상된 세포의 복구와 콜라겐·엘라스틴 생성을 촉진합니다.
노화로 인한 탄력 저하뿐 아니라 다양한 피부 재생 목적에도 활용됩니다.
피부 직접 주사 주요 효과
01
피부재생
세포 성장인자 작용으로 손상된 진피 복구
02
탄력·주름 개선
콜라겐·엘라스틴 재생 유도
03
피부톤 회복
멜라닌 억제 및 피부결 개선
04
아토피 피부염 완화
항염·면역조절로 피부 장벽 강화
05
상처 재생 / 흉터 완화
손상조직 회복 및 흉터 리모델링
06
탈모 개선
두피에 직접 주사 시 모낭 활성화·혈류 개선
2
IV 정맥주입 방식
“전신 순환으로 세포부터 리셋하는 항노화 케어”
정맥주입 방식은 BC를 혈관으로 직접 투여하여 전신 순환을 통해 노화된 조직, 염증 부위, 손상 세포를 찾아가 복구합니다.
피부 미용을 넘어, 몸 전체의 활력 회복과 면역 조절에 효과적입니다.
IV 정맥주입 주요 효과
01
항노화 효과
세포 대사활성, 노화 유전자 억제
02
면역 균형 회복
염증 사이토카인 감소, 면역세포 조절
03
피로 회복·컨디션 개선
체내 산화스트레스 완화
04
만성 염증 완화
관절, 간, 소화기 등 전신 염증 반응 완화
05
신경계 안정화
신경세포 보호, 뇌 혈류·인지기능 개선
06
항산화 작용
활성산소 제거, 세포 손상 예방
피부 주사 vs IV 정맥주입
Skin injection
피부 주사
- 국소 집중 작용
- 피부탄력, 주름, 피부염 효과
- 빠른 회복 속도
IV infusion
IV 정맥주입
- 전신 순환 작용
- 항노화, 면역 조절, 컨디션 회복 효과
- 점진적 회복 속도
르로제 BC 안티에이징 시술 과정
주의사항 및 관리법
01효과는 개인차가 있습니다.
개인별 피부 상태나 체질에 따라 시술 효과에는 차이가 있을 수 있습니다.
02전문 의료진과 충분히 상담하세요.
시술은 반드시 의료진의 전문적인 판단에 따라 진행되며,
시술 전·후 주의사항 안내를 충분히 받으셔야 합니다.
03일시적인 반응이 나타날 수 있습니다.
간혹 발적, 가려움, 미열 등의 일시적인 반응이 발생할 수 있으나,
대부분 1~2일 이내 자연스럽게 호전됩니다.
르로제는 곡선을
디자인합니다

현실적인 결과만을 쫒는 수술은 하지 않습니다.
단 하나의 몸, 단 하나의 곡선을 위해 여성의 시선으로,
여성의 몸을 섬세하게 이해해 완성형 실루엣을 디자인합니다.
* 이스라엘 ALMA사 자문 의료진
* TuneFace & TuneBody 공식 트레이너
르로제 대표원장 김혜윤